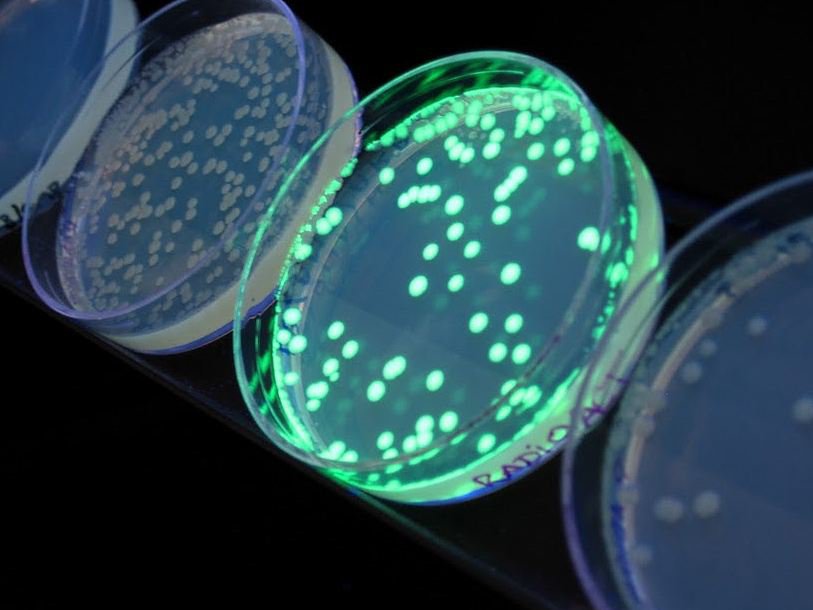

Флуоресцентные белки позволяют изучать локализацию белков в клетке и в организме
Всеволод Белоусов 16 мая 2013 года состоялась очередная лекция в рамках проекта «Публичные лекции Полит.ру». Биолог Всеволод Вадимович Белоусов – заведующий Группой биологии активных форм кислорода Института биоорганической химии им. М.М. Шемякина и Ю.А. Овчинникова РАН – выступил с лекцией на тему: «Флуоресцентные белки и биосенсоры».
Механизм флуоресценции состоит в том, что, когда молекула поглощает кванты света, электроны переходят на более высокие энергетические уровни, а потом возвращаются к исходному состоянию, испуская фотоны. Но, поскольку часть энергии теряется, излученный свет имеет меньшую энергию и соответственно большую длину волну, чем поглощенный. Поглощая, например, синий свет, молекула испускает зеленый. Флуоресценцию следует отличать от другого явления – люминесценции, когда свечение появляется в результате выделения энергии при химических реакциях.
Биолюминисценцию и биофлуоресценцию изучал в 1960-е годы японский ученый Осаму Симомура, работавший в Принстоне. Он выделил из мелких ракообразных (Cypridina hilgendorfii) люцеферин, позволяющий им светиться. Затем из организма медузы Aequorea victoria Симомура выделил белок экворин, обеспечивающий люминесценцию в присутствии ионов кальция. Однако in vitro экворин излучал синий свет, а сами медузы светятся зеленым. Продолжив работу, Симомура обнаружил, что это свечение обеспечивает другой белок – зеленый флуоресцентный белок (green fluorescent protein, GFP). Именно открытие GFP дало в руки биологов мощный исследовательский инструмент, хотя в начале 1960-х об этом никто не подозревал.
В 1992 году Дуглас Прэшем (Douglas C. Prasher) из Лаборатории морской биологии в Массачусетсе клонировал ген, кодирующий GFP. В 1994 Мартин Чалфи (Martin Chalfie) впервые применил этот белок in vivo, индуцировав нужный ген в кишечную палочку (Escherichia coli) и нематоду Caenorhabditis elegans. В дальнейшем Роджер Тсиен усовершенствовал этот белок. За работу над флуоресцентным белком Сикомура, Чалфи и Тсиен получили в 2008 году Нобелевскую премию по химии.
В дальнейшем работа над флуоресцентными белками продолжилась. Были получены белки, дающие излучение других цветов: красного, желтого, голубого и т. д. В эту работу большой вклад внесла группа ученых под руководством Сергея Анатольевича Лукьянова. Источниками некоторых флуоресцентных белков, например красного, стали кораллы. Причем коралл, из которого этот белок был выделен, ученые купили в ближайшем зоомагазине.
Однако зачем ученым по всему миру тратить время и силы на выделение флуоресцентных белков? Почему Нобелевский комитет счел эту работу достойной премии? Всё дело в том, что благодаря флуоресцентным белкам исследователи получили возможность увидеть процессы происходящие в организме и даже контролировать результаты собственных действий. Это стало возможным благодаря генной инженерии. Вставив в нужное место генома ген, кодирующий флуоресцентный белок, исследователь по появлению флуоресценции может определять, когда и как этот участок генома «работает».
Когда в распоряжении ученого есть несколько разных флуоресцентных белков, их можно внедрить в один организм или в одну клетку и наблюдать параллельно несколько процессов. При помощи такого многоцветного мечения можно сделать так, чтобы ядро клетки, например, светилось красным, цитоскелет – синим, митохондии – зеленым и так далее.
Для наблюдений с использованием GFP и других флуоресцентных белков нужны специальные приборы. В флуоресцентных микроскопах на образец – клеточную культуру или зафиксированный живой организм – направляется поток фотонов, чтобы исследователь мог наблюдать флуоресценцию. Проточный флуориметр освещает образец клеток разными лазерами и подсчитывает число клеток, отреагировавших на то или иной излучение флуоресценцией.
Флуоресцентные белки используют для визуализации активности промоторов. Промоторы – это последовательности нуклеотидов в ДНК, предшествующие основной, кодирующей последовательности гена. По промотору РНК-полимераза «узнает», когда начинать считывание последовательности нуклеотидов для синтеза информационной РНК, а затем – соответствующего белка. Если мы после нужного нам промотора поставим ген, кодирующий GFP, то вместо белка, за синтез которого отвечал ген, клетка будет синтезировать GFP. В результате по зеленой флуоресценции исследователь может определить, когда включается данный промотор, в каких условиях, сколько работает и т. д. Поскольку есть промоторы, которые включаются только в определенных типах клеток, можно наблюдать флуоресценцию только клеток данного типа. Можно, например, увидеть под микроскопом свечение сенсорных нейронов личинки мухи дрозофилы. Или стволовые клетки мозга мыши.
Глазодвигательный нерв и нейроны зубчатой извилины мыши, окрашенные по методу Brainbow С помощью флуоресцентных белков можно изучать и локализацию различных белков в клетке и в организме. Тогда последовательность, кодирующую флуоресцентный белок, вставляют в ДНК вместе с той, которая кодирует белок, интересующий ученого. В результате по флуоресценции можно определять, какие белки находятся в ядре, какие в комплексе Гольджи, какие в мембране и так далее. Жан Ливе с коллегами в 2007 году предложили даже метод, позволяющий увидеть каждый отдельный нейрон мозга мыши. Метод получил название Brainbow. Он состоит в том, что в результате определенных манипуляций каждая клетка мозга получает случайный набор флуоресцентных белков. А, как известно, из сочетания трех цветов: красного, зеленого и синего – можно получить любой цвет. В результате нейроны приобретают индивидуальную уникальную окраску.
Видеозаписи, полученные на живых организмах с использованием флуоресцентных белков, порой завораживают. Мы видим каждую отдельную клетку в развивающейся личинке дрозофилы. Вспышки сигнализируют об активности нейронов в мозге малька рыбки Danio rerio. Тело этих мальков почти прозрачно, что делает их особенно удобным объектом для исследования с помощью флуоресцентных белков. Сортеры, основанные на этом же принципе, могут разделять клетки, дающие разный эффект при флуоресценции.
Флуоресцентные белки используются и в фармацевтических исследованиях. Когда из многих сотен кандидатов подбирается вещество, дающее нужный эффект, это удобно делать на клеточных культурах, модифицированных таким образом, что эффект сопровождается экспрессией флуоресцентного белка. Тогда по наличию и интенсивности свечения можно быстро определить подходящее вещество.
В качестве курьеза Всеволод Белоусов рассказал о предложении создать трансгенные дрожжи с GFP, при помощи которых можно было бы получать нефильтрованное пиво, светящееся в синем освещении ночного клуба приятным зеленоватым светом. К сожалению для любителей экстравагантных напитков подобные идеи наталкиваются на серьезное препятствие: законодательства большинства стран сильно ограничивают использование трансгенных организмов в пищевой промышленности.
Полный текст лекции в будущем будет доступен на сайте Полит.ру.